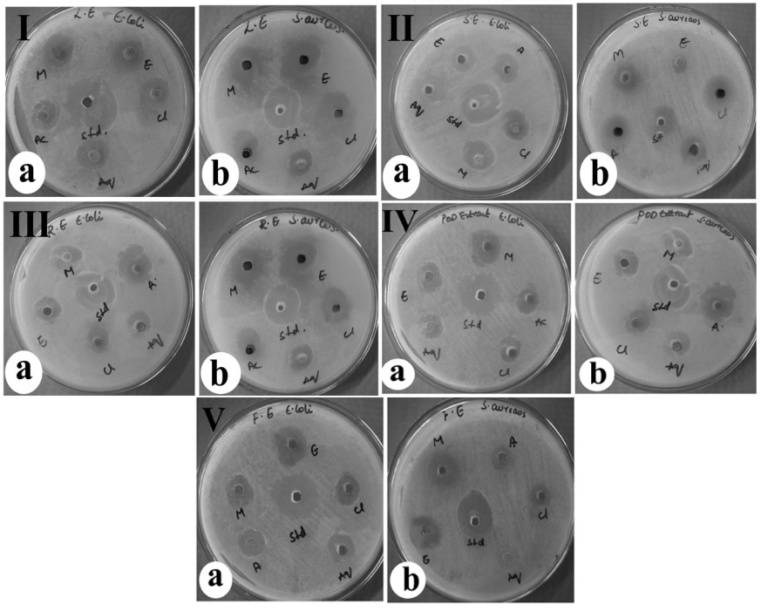

Plant Biotechnology Research Group, Department of Biotechnology, Kakatiya University, Warangal 506009(TS), India.
Email: swamynr.dr@gmail.com
Received: 09 Dec 2014 Revised and Accepted: 29 Dec 2014
ABSTRACT
Objective: The aim of this study was to investigate the antibacterial activity of leaf, seed, root, pod and flower extracts of C. cajan with various solvents such as aqueous, acetone, chloroform, ethanol and methanol.
Methods: C. cajan was evaluated against certain pathogenic species of gram negative and gram positive bacteria (Staphylococcus aureus and Escherichia coli) by agar well diffusion method.
Results: It was observed that the methanolic and ethanolic extracts had shown potent antibacterial activity against gram +ve and gram -ve bacterial species. Among the five solvents used, methanolic extracts showed higher activity against S. aureus (ZI of leaf, 25.5±0.08 mm; seed, 22.6±0.01 mm; root, 22.1±0.09 mm; pod, 20.8±0.14 mm and flower, 21.9±0.05 mm). Whereas ethanolic extracts showed higher activity against E. coli of all the solvent extracts used in C. cajan (ZI of leaf, 25.1±0.05 mm; seed, 22.4±0.12 mm; root, 21.9±0.04 mm; pod, 20.7±0.12 mm and flower, 21.5±0.10 mm). The minimum inhibitory concentration of methanolic and ethanolic leaf, seed, root, pod and flower extracts respectively was determined to be ranging between 0.38 and 0.512mg/mL for both the bacterial species.
Conclusion: The results of this study support that the crop species C. cajan had potential antibacterial activity against S. aureus and E. coli and these extracts may be used for production of drugs commercially to treat diseases caused by the respective pathogens.
Keywords: Cajanus cajan, Phytochemicals, Staphylococcus auereus, Escherichia coli, Antibacterial activity.
INTRODUCTION
Cajanus cajan (L.) Millsp. is an annual shrub belongs to the family Fabaceae has been widely used as food in tropical countries. Seeds serve as vegetables and are very nutritious. The leaves are widely used for treatment of sore gums, as the mouth wash, for toothache and dysentery [1]. The leaves or seeds of pigeon pea are used to treat stomach ache in some African countries. The decoction of leaves or pounded seeds mixed with water is given for gastrointestinal diseases. Roots and stalks are chewed on to retrieve toothache in Africa. For stomach problems preparation of roots is given [2-4]. Plants are found to be useful to man not only as food or as source of raw materials for industrial purposes, but they are used as sources of medicaments [5]. C. cajan has been found to be antibacterial, anti sickling, regulates blood pressure and antiviral (hepatitis, catarrh and measles). It is used in treatment of psychosomatic disorder called Abutilon [6].
The search for the plants with antibacterial activity has gained importance in recent years due to the development of multidrug resistance by microbes and often the occurrence of undesirable side effects of some antibiotics [7]. The possible mechanisms of multidrug resistance are due to production of β‐lactamases, metallo‐ β‐lactamases and carbapenemases [8]. About 80% population use traditional medicine which has compounds derived from medicinal plants in most of the developed countries [9]. E. coli and S. aureus (enteropathogens) are frequently incriminated in food poisoning incidence associated with gastroenteritis [10].
Preliminary phytochemical screening has already been reported in seed, leaf, root and stem extracts of C. cajan [11, 12]. In view of importance of C. cajan in ethanobotany as health remedy, the present study was designed to investigate the antibacterial activity of leaf, seed, root, pod and flowers with various solvent extracts such as aqueous, acetone, chloroform, ethanol and methanol against the enteropathogenic bacteria in order to determine the potency of the crude drug by using agar well diffusion method.
MATERIALS AND METHODS
Collection and processing of plant materials
The plant parts of C. cajan was collected from the research field, Department of Biotechnology, Kakatiya University, Warangal. The plant parts were washed under running tap water and dried for about 2-3 weeks at room temperature under shade conditions. The dried leaves, seeds, roots, pods and flowers were ground separately into powdery form using an electric grinder, then stored and labelled in sterilized container.
Preparation of plant extracts
Powdered each plant material (15g/100 ml*) was extracted separately by successive soaking for 1 day, with aqueous and organic solvents viz., acetone, chloroform, ethanol and methanol for each sample in separate containers. The extracts were then filtered using whatman No.1 filter paper and evaporated to dryness at room temperature. The concentrated extracts were stored in air tight container until use.
Chemicals
All the chemicals and antibiotics used were of analytical grade and were purchased from Himedia (Mumbai, India).
Test organisms
Gram negative bacterial strain Escherichia coli and gram positive strain Staphylococcus aureus were obtained from Department of Microbiology, Kakatiya University, Warangal. They were maintained at 40c on the slants of nutrient agar medium for further use.
Antibacterial activity
In vitro antibacterial activity was analysed for crude extracts of leaf, seed, root, pod and flower parts of C. cajan against pathogenic bacteria species S. aureus and E. coli using agar well diffusion method as described by Opera and Anasa [13]. 0.2 ml* of 24h broth culture of the test microorganisms was introduced aseptically and spread evenly on the surface of gelled sterile Muller-Hinton agar plates using bent sterile glass rod. 5 wells of 6.0 mm* diameter were punched using a sterile cork borer for various solvent extracts in each petri plate containg overnight lawn culture of E. Coli and S. aureus respectively. The various plant extracts and standard streptomycin of fixed volumes (0.1 ml*) were added into wells and then incubated at 370C for 24h. Antibacterial activity was evaluated by measuring the diameter of the zone of inhibition (ZI in mm).
Minimum Inhibitory Concentration (MIC)
The MIC was determined for methanolic extract against S. aureus and ethanolic extract against E. coli of leaf, seed, root, pod and flower parts of C. cajan. MIC was found out through the broth dilution method [14]. 200 µl* of overnight grown bacterial cultures (108cells/ml) were transferred into test tubes containing different concentrations (0.050-0.500 mg/ml) of leaf, seed, root, pod and flower extracts separately, prepared by dissolving in 1 ml* nutrient broth.
Streptomycin (0.100mg/ml) was used as positive control and solvent methanol (100 µl) was used as negative control. The test tubes were incubated for 24 hrs at 370C and were analysed for visible turbidity. The MIC values can be determined as the lowest possible concentration that inhibits the growth of microorganism [15, 16].
Statistical analysis
The antibacterial activity of leaf, seed, root, pod and flower extracts of C. cajan was indicated by clear zones of growth inhibition. All the experiments were performed in triplicate and the data were statistically analysed as Mean ± SE (standard error) by following the method of Pillai and Sinha [17].
RESULTS
Antibacterial activity
In vitro antibacterial activity of different plant parts of C. cajan was performed using agar well diffusion method. The results of the study showed that the aqueous and organic solvent extracts viz. (acetone, chloroform, ethanol, and methanol) of leaf, seed, root, pod and flower parts of C. cajan had shown prominent antibacterial activity against the pathogenic bacteria studied (tables 1-3, fig. 1). Highest activity of methanolic extracts against S. aureus and ethanolic extracts against E. coli was observed in all the plant parts of C. cajan tested. On the other hand, chloroform extract showed least activity in leaf, seed, root, pod and flower extracts against bacteria studied. Among the five plant parts tested pod extracts showed the least activity against both the pathogenic bacteria. Highest ZI was exhibited by methanol leaf extract (25.5±0.08) against the gram +ve bacteria S. aureus, followed by seed (22.6±0.01), root (22.1±0.09), flower (21.9±0.05) and pod extracts (20.8±0.14) respectively (table 1).
Minimum Inhibitory Concentration (MIC)
The results showed that the MIC value of leaf, seed, root, pod and flower was ranging between 0.38 and 0.512mg/mL for both the pathogenic bacteria. It has been identified that an MIC 0.38 mg/mL was recorded for methanolic leaf extracts and 0.385mg/mL for ethanol leaf extracts against S. aureus and E. coli respectively (table 3).
Table 1: In vitro antibacterial activity of leaf, seed, root, pod and floral extracts of C. cajan against S. aureus
S. No. |
Solvents used |
ZI (mm) for S. aureus |
||||
Leaf extracts |
Seed extracts |
Root extracts |
Pod extracts |
Floral extracts |
||
1. |
Acetone |
16.0±0.07 |
18.2±0.09 |
19.3±0.05 |
14.4±0.03 |
15.9±0.04 |
2. |
Chloroform |
15.2±0.02 |
13.9±0.07 |
13.5±0.12 |
12.3±0.01 |
13.1±0.02 |
3. |
Ethanol |
23.0±0.05 |
21.7±0.04 |
21.3±0.02 |
20.1±0.04 |
21.0±0.07 |
4. |
Methanol |
25.5±0.08 |
22.6±0.01 |
22.1±0.09 |
20.8±0.14 |
21.9±0.05 |
5. |
Aqueous |
15.7±0.09 |
21.8±0.01 |
21.3±0.12 |
14.7±0.05 |
20.8±0.10 |
6. |
Streptomycin(0.1mg/mL) |
26.8±0.06 |
26.1±0.02 |
25.9±0.04 |
25.5±0.03 |
26.0±0.06 |
Each value is expressed as mean ± SE (n=3), Highest zone of inhibition was exhibited by ethanol leaf extract (25.1±0.05), followed by seed (22.4±0.12), root (21.9±0.04), flower (21.5±0.10) and pod extracts (20.7±0.12) respectively against the gram –ve bacteria E. coli (table 2).
Table 2: In vitro antibacterial activity of leaf, seed, root, pod and floral extracts of C.cajan against Ecoli
S. No. |
Solvents used |
ZI (mm) for E. coli |
||||
Leaf extracts |
Seed extracts |
Root extracts |
Pod extracts |
Floral extracts |
||
1. |
Acetone |
11.7±0.09 |
17.9±0.04 |
17.5±0.07 |
12.3±0.02 |
12.1±0.04 |
2. |
Chloroform |
13.8±0.01 |
13.6±0.10 |
12.9±0.02 |
10.4±0.05 |
12.6±0.02 |
3. |
Ethanol |
25.1±0.05 |
22.4±0.12 |
21.9±0.04 |
20.7±0.12 |
21.5±0.10 |
4. |
Methanol |
23.0±0.07 |
20.7±0.04 |
20.5±0.02 |
19.3±0.01 |
20.1±0.07 |
5. |
Aqueous |
15.6±0.03 |
14.1±0.01 |
14.9±0.07 |
11.5±0.03 |
13.4±0.05 |
6. |
Streptomycin(0.1mg/mL) |
26.5±0.05 |
25.9±0.07 |
25.5±0.01 |
24.8±0.09 |
25.9±0.06 |
Each value is expressed as mean ± SE (n=3)
Table 3: Mean MIC values of leaf, seed, root, pod and floral methanolic extracts of C. cajan against S. aureus and ethanolic extracts against E. coli
S. No. |
Plant parts |
Mean MIC (mg/ml) |
|
S. aureus |
E. coli |
||
1. |
Leaf |
0.38 |
0.385 |
2. |
Seed |
0.389 |
0.391 |
3. |
Root |
0.404 |
0.409 |
4. |
Pod |
0.51 |
0.512 |
5. |
Flower |
0.44 |
0.445 |
DISCUSSION
Highest activity of methanolic extracts against S. aureus and ethanolic extracts against E. coli was observed in all the plant parts of C. cajan tested.
The results of our study are in conformity with the reports of Scholastica Obiorah et al. [18] they have reported that methanolic leaf extracts showed higher inhibitory activity against S. aureus in C. cajan and also with studies of Ezeifeka et al. [19] have reported that S. aureus was found to be sensitive for aqueous and ethanolic extracts of leaf, seed extracts while E. coli was found to be resistant to aqueous, seed extracts of C. cajan as we found in the present investigations. The results of the study showed that the organic solvent extracts were more effective than the aqueous extracts. The difference in the observed activities of various extracts is due to varying degrees of solubility of the bioactive constituents in the solvents used. It has been described that the various solvents have diverse solubility capacities for different phytoconstituents [20]. The effect of aqueous and various organic solvent extracts of different plant parts of C. cajan for antibacterial activity was determined to be varied among the organisms tested. The activity showed by all the extracts was almost similar or somewhat greater than the standard (streptomycin) which consistently displayed much activity when compared with the extracts on S. aureus and E. coli. This may be attributed to the fact that streptomycin is a pure compound compared with the doses of leaf extracts of C. cajan used.
Fig. 1 (I-V): In vitro antibacterial activity of leaf, seed, root, pod and flower extracts ofC. cajan: I. Leaf extracts; II. Seed extracts; III. Root extracts; IV. Pod extracts; V. Flower extracts (a: Escherichia coli; b: Staphylococcus aureus) (Standard=Streptomycin) (Aq = Aqueous; A = Acetone; Cl = Chloroform; E = Ethanol; M = Methanol extracts)
All the extracts of C. cajan inhibited the growth of S. aureus and E. coli to varying degrees depending on the dose tested. The extracts were found to show inhibitory activity against gram positive and gram negative bacteria indicating the broad spectrum nature of the antimicrobial compounds present in the extracts as the methanolic extract showed high control over the growth of bacteria S. aureus and ethanolic extracts against E. coli. Similar observations were also made by Prathima and Prathima Mathad [21] who reported that the ethanolic extracts exhibited highest activity on both gram +ve and gram –ve bacteria compared to the aqueous, chloroform, methanol and petroleum ether extracts of C. cajan. Up on both the bacteria tested gram positive bacteria is slightly more susceptible to all the extracts than gram negative bacteria. Our results are also in conformity with the work of Jigna et al. [22] and Dougharia et al. [23].
The methanolic and ethanolic extracts of all the plant parts of C. cajan showed more inhibitory effects in comparison to the other extracts tested. Akunyilli et al. [24] have also reported the similar results on antibacterial activity of stem bark of Kigelia pinnata where, ethanolic extracts showed more inhibitory effect than the aqueous extracts. These findings suggest that the active ingradients of the plant parts were better extracted with ethanol and methanol than other extracts. Hence, methanolic extracts against S. aureus and ethanolic extracts against E. coli of C. cajan was studied to determine minimum inhibitory concentration. Low MIC value is an indication of high activity and vice versa.
CONCLUSION
The antibacterial activity of C. cajan against both the gram positive and gram negative bacteria is an indication that the plant is a potential source for production of drugs with a broad spectrum of antibacterial activity. Methanol extracts of all the plant parts showed better antibacterial activity against S. aureus, while ethanolic extracts were found to be better on E. coli. From the results of our study it is concluded that antibacterial extracts of C. cajan may be helpful in treatment of many infectious enteric diseases, as the extracts of all the major parts of C. cajan were effective in controlling the growth of enteropathogenic bacteria.
ACKNOWLEDGEMENT
Ms. Mahitha Banala is greatly thankful to University Grants Commission, New Delhi for financial assistance as UGC-BSR Research Fellow (UGC Sanction Lr. No. F.4-1/2006(BSR) /7-211/2009(BSR); dt. 26-02-2013) and to the Department of Microbiology, Kakatiya University for supplying the pathogenic bacteria.
CONFLICT OF INTERESTS
Declared None.
REFERENCES